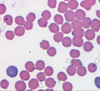

Qu’est-ce que la règle du 1-2-3 pour biopsier les masses chez le chat ?
- Biopsie toute masse qui continue de grossir aprèes 1 mois
- Biopsie toute masse plus que 2 cm
- Bopsie toute masse présente 3 mois post-vaccination
Qu’est-ce que la triadite féline ?
80 % des chats atteints d’une cholangite ont une IBD concomitante (ou lymphome à petites cellules),
50 % ont une pancréatite et 38% ont une inflammation/infection présente dans les trois organes.
Cela peut résulter en un reflux du contenu dudoénal dans le canal cholédoque.
Puisque le canal pancréatique rejoint le canal cholédoque chez les chats, cela peut entrainer une inflammation et une infection a/n de la vessie et du pancréas = triadite
Qu’est-ce qui est important de ne PAS faire avec un chat en pancréatite (vs le chien) ?
NE PAS le mettre au jeune ! Les chats peuvent développer une lipidose hépatique ou peuvent l’aggraver sidéjèa présente.
Quel type d’ulcère cornéen est pathognomonique chez une chat atteint d’herpèsvirus félin type 1 ?
Ulcère dendritique
Quel anti-viral oral ne faut-il pas utiliser chez un chat atteint d’herpèsvirus ?
Valacyclovir (toxique = fatal)
L’asthme félin est un diagnostic d’exclusion, quelles sont les maladies à exclure ?
- Maladies cardiaques
- Pneumonie
- Pneumothorax ou effusion pleurale
- Néoplasme pulmonaire
- CÉ inhalé
- Parasites respiratoires
Quel patron pulmonaire est associé à l’asthme félin ?
Patron bronchique (beigne, chemin de fer)
Quel est le traitement de l’asthme félin (intermittent vs consistent vs urgence) ?
Intermittent : Albuterol (bronchodilatateur) au besoin
Consistent : Fluticasone Propionate (stéroide inhalé) sans effets secondaires systémiques
Urgence : Oxygène, bronchodilatateur et sédation
Exemple de bronchodilatateur : Terbutaline (bêta-2 agoniste)
Quels signes cliniques ou résultats de tests nous font pencher vers l’asthme félin ?
Patron bronchique à RX
Dyspnée expiratoire (poussée à l’expiration)
ÉOSINOPHILIE au LBA ou lavage endotrachéal !
Éternuement et toux (moins spécifique)
Obstruction urétrale
Quels sont les principaux problèmes cliniques biochimiques à résoudre lors d’une obstruction urétrale chez un chat mâle ?
Hyperkaliémie (diminution excrétion K + acidose)
Acidose métabolique (diminuion excrétion H+)
Azotémie/Hyperphosphatémie (diminution excrétion urée et autres déchets)
Hypocalcémie (secondaire à hyperphosphatémie)
Le gluconate de calcium IV peut être utilisé pour traiter l’hyperkaliémie. De quelle façon agit-il ?
NE DIMINUE PAS LA KALIÉMIE
Le calcium va simplement restorer le potentiel membranaire et donc revenir à une dépolarisation normale
Il est le seul des traitements à ne pas agir sur la translocation cellulaire du potassium
Si je souhaite diminuer la kaliémie chez mon patient hyperkaliémique, que devrais-je lui donner ?
- Fluide IV (NaCl 0.9%) pour diluer le potassium
- Dextrose IV + Insuline pour faire entre K+ dans les cellules
- Régler l’acidose métabolique si présente (shift K+) avec bicarbonate de sodium
- Autre option : Gluconate de calcium
NE JAMAIS DONNER INSULINE TOUT SEUL = HYPOGLYCÉMIE = CONVULSIONS !
Quelles sont les 8 grandes étapes du traitement de l’obstruction uréthrale ?
- Réhydrater avec des fluides sans K+ (NaCl 0,9%)
- Corriger les anomalies électrolytiques importantes (donner du Ca, insuline + dextrose, bicarbonate)
- Corriger l’obstruction (rétropulsion + mise en place d’un KT urinaire pour monitoring)
- S’attendre à une diuèse profonde post-obstructive (monitoring + fluide IV)
- Une fois le patient stabilisé, corriger la cause sous-jacente de l’obstruction (RX, écho, urologie, culture)
- Continuer sédation et analgésie
- Retirer KT une fois toutes les anomalies résolues (azotémie, électrolytes, diurèse post-obstructive)
- Observer 12-24h pour s’assure que le patient urine spontanément
Le test des anticorps pour FIV est difficilement interprétable pour quels sujets ?
Jeunes chats et chats vaccinés
Quel est le truc pour différencier le mode de transmission du FeLV vs FIV ?
FeLV : Chats qui s’aiment
FIV : Chats qui se détestent
FeLV : Grooming mutuel, contact intime
FIV : Morsure
LES DEUX SE TRANSMETTENT PAR LA SALIVE !!!
Décrire le test pour détecter FeLV
ELISA
Détection de l’antigène p27 dans le sérum
Non affecté par vaccin ou anticorps maternels
Si ELISA est +, il faut différencier si c’est transitoire ou une réelle infection : IFA immédiat
**Si IFA est - **: ELISA dans 1-3 mois pour savoir si virus a été neutralisé
Ne veut pas toujours dire que le chat s’est débarassé du virus, car il peut s’être séquestré dans la MO, juste le IFA sera + dans ce cas
**98% des chats infectés vont avoir une infection transitoire, auto-limitante, développer des Ac et devenir antigène négatif **
IFA (Immunofluorescence Ac) test opur p27 dans les leucocytes et plaquettes
Décrire le(s) test(s) pour FIV
ELISA et Western blot
Tests pour Anticorps
Pas pour chaton de moins de 6 mois
Toujours confirmer ELISA avec un Western Blot
Un chat atteint de FeLV devrait-il être vacciné contre le FeLV ?
Non
Malgré vx…
Chat reste FeLV +
Chat reste infectieux
Chat a le même risque de développer des signes cliniques
Le vaccin contre le FIV ou le FeLV qui résulte en un test positif ?
FIV
Décrire les points-clés de l’hyperthyroidisme
1. Raison de présentation
2. Éléments-clés de l’examen physique
3. Diagnostic
4. Traitement
- Perte de poids et polyphagie, hyperactivité, vomissement
- “Slip” (nodules thyroidiens), tachycardie et souffle cardiaque - Cardiomyopathie thyrotoxique
- Niveau de T4 total sérique (+/- T4 libre si zone grise)
- Méthimazole oral, thyroidectomie ou I-131
Autres anomalies fréquentes : Hypertension, érythrocytose, enzymes hépatiques augmentées
Quels paramètres faut-il surveiller lorsqu’on commence un traitement pour l’hyperT4, car l’hyperT4 peut l’avoir cacher ?
Paramètres rénaux
Quelles sont les effets secondaires importants du méthimazole ?
Excoriations faciales
Thrombocytopénie, anémie, agranulocytose
Hépathopathie
Peut être arrêté si les valeurs rénales augmentent
Quelles sont les effets secondaires associés à la thyroidectomie ?
chirurgie habituellement bilatérale
HypoPTH iatrogénique (HypoCa)
HypoT4
Syndrome de Horner
Paralysie laryngée (changement de voix)
Quels sont les effets secondaires associés à I-131 ?
HypoT4 iatrogénique (supplémentation)
Sous-traité = retraitement nécessaire